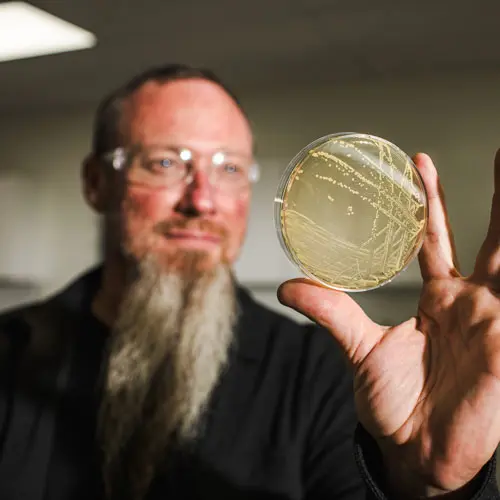
fermenting-a-passion

THE ROAD
TO WILDERNESS
TRAIL
Banding together

FERMENTING A PASSION
LAUNCHING IN THE CITY OF FIRSTS

A fitting hometown for a downright radical operation.
MATURING OUR REPUTATION

Soon after, we joined the ranks of the state’s most elite bourbon producers when we were named the official 18th stop on the historic Kentucky Bourbon Trail in 2020.
OPTIMIZING OLD-WORLD TRADITIONS

In an industry that lives and dies by the old ways of its ancestors, we’re proud to be blazing trails into the future and bringing expert-backed, unconventional thinking to our craft.